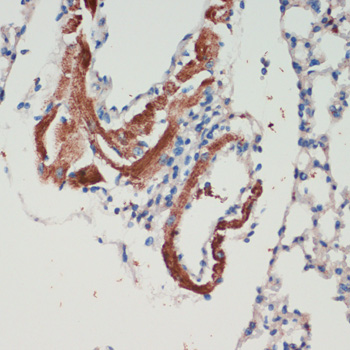
Immunohistochemistry - LRRK2 Polyclonal Antibody
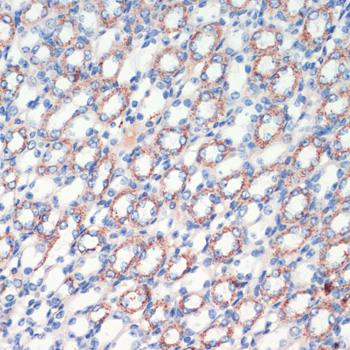
Immunohistochemistry - LRRK2 Polyclonal Antibody

-
Product Name
LRRK2 Polyclonal Antibody
- Documents
-
Description
Polyclonal antibody to LRRK2
-
Tested applications
IHC
-
Species reactivity
Human, Mouse, Rat
-
Alternative names
LRRK2 antibody; AURA17 antibody; DARDARIN antibody; PARK8 antibody; RIPK7 antibody; ROCO2 antibody; leucine rich repeat kinase 2 antibody
-
Isotype
Rabbit IgG
-
Preparation
Antigen: Recombinant fusion protein containing a sequence corresponding to amino acids 2355-2527 of human LRRK2 (NP_940980.3).
-
Clonality
Polyclonal
-
Formulation
PBS with 0.02% sodium azide, 50% glycerol, pH7.3.
-
Storage instructions
Store at -20℃. Avoid freeze / thaw cycles.
-
Applications
IHC 1:50 - 1:200
-
Validations

Immunohistochemistry - LRRK2 Polyclonal Antibody
Immunohistochemistry of paraffin-embedded rat liver using LRRK2 antibody at dilution of 1:200 (40x lens).

Immunohistochemistry - LRRK2 Polyclonal Antibody
Immunohistochemistry of paraffin-embedded rat brain using LRRK2 antibody at dilution of 1:200 (40x lens).

Immunohistochemistry - LRRK2 Polyclonal Antibody
Immunohistochemistry of paraffin-embedded rat heart using LRRK2 antibody at dilution of 1:200 (40x lens).
Immunohistochemistry - LRRK2 Polyclonal Antibody
Immunohistochemistry of paraffin-embedded mouse lung using LRRK2 antibody at dilution of 1:200 (40x lens).

Immunohistochemistry - LRRK2 Polyclonal Antibody
Immunohistochemistry of paraffin-embedded mouse spinal cord using LRRK2 antibody at dilution of 1:200 (40x lens).

Immunohistochemistry - LRRK2 Polyclonal Antibody
Immunohistochemistry of paraffin-embedded mouse spleen using LRRK2 antibody at dilution of 1:200 (40x lens).
Immunohistochemistry - LRRK2 Polyclonal Antibody
Immunohistochemistry of paraffin-embedded mouse kidney using LRRK2 antibody at dilution of 1:200 (40x lens).
-
Background
Positively regulates autophagy through a calcium-dependent activation of the CaMKK/AMPK signaling pathway. The process involves activation of nicotinic acid adenine dinucleotide phosphate (NAADP) receptors, increase in lysosomal pH, and calcium release from lysosomes. Together with RAB29, plays a role in the retrograde trafficking pathway for recycling proteins, such as mannose 6 phosphate receptor (M6PR), between lysosomes and the Golgi apparatus in a retromer-dependent manner. Regulates neuronal process morphology in the intact central nervous system (CNS). Plays a role in synaptic vesicle trafficking. Phosphorylates PRDX3. Has GTPase activity. May play a role in the phosphorylation of proteins central to Parkinson disease. Plays an important role in recuiting SEC16A to endoplasmic reticulum exit sites (ERES) and in regulating ER to Golgi vesicle-mediated transport and ERES organization.
Related Products / Services
Please note: All products are "FOR RESEARCH USE ONLY AND ARE NOT INTENDED FOR DIAGNOSTIC OR THERAPEUTIC USE"
